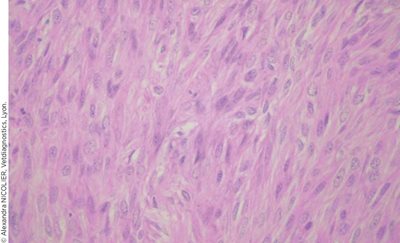

Trois furettes âgées de 5 ans et demi à 7 ans sont individuellement présentées pour une alopécie non prurigineuse, essentiellement de la queue et la croupe, évoluant depuis trois semaines. Les trois furettes sont en œstrus depuis 8 à 12 semaines. Elles ne présentent pas d’antécédents médicaux notables et ne sont pas stérilisées.
Deux des furettes sont des anciennes reproductrices. La troisième n’a jamais reproduit et a régulièrement présenté des chaleurs qui se sont interrompues naturellement au bout de quelques mois.
Cas clinique
Examen clinique
L’état général est bon pour chaque furette. La furette 1 est maigre. Les furettes 2 et 3 présentent une dilatation abdominale (Photo 1).
Une alopécie est constatée sur les trois animaux ; elle concerne essentiellement la queue, la croupe et les flancs. Une alopécie de la face ventrale concerne deux furettes et une alopécie de la tête est observée sur l’une d’elles (Photo 2).
Aucune autre anomalie n’est observée sur la peau. Un œdème vulvaire est présent chez chaque furette.
L’examen clinique montre la présence d’une masse abdominale pour chaque patient. Les masses sont mobilisables et ont une consistance dure et un contour irrégulier. Elles sont très volumineuses pour les furettes 2 et 3 (approximativement 10-15 centimètres). Leur palpation n’est pas douloureuse.

Photo 1 : Distension abdominale de la furette 2

Photo 2 : Alopécie non prurigineuse de la furette 1
Hypothèses diagnostiques
L’observation d’une alopécie non prurigineuse chez des furettes non stérilisées en œstrus prolongé nous oriente vers une hypothèse d’hyperœstrogénisme.
Les hypothèses diagnostiques concernant la masse abdominale incluent une organomégalie (foie, rein, rate, ganglion, appareil génital), une tumeur, un granulome infectieux (mycobactérie, coronavirus systémique), un kyste, un hématome et un abcès intra-abdominal.
Examens complémentaires
Un examen sanguin biochimique et hématologique est réalisé pour chaque furette. Les résultats biochimiques sont dans les limites des valeurs usuelles. Les résultats de l’hématologie indiquent une numération érythrocytaire en deçà de l’intervalle de référence (Tableau 1).
La radiographie montre une masse abdominale non identifiable. Aucune métastase pulmonaire ou osseuse d’une éventuelle tumeur n’est mise en évidence.
L’échographie conclut à une tumeur ovarienne et une hyperplasie utérine modérée pour chaque furette.

Traitement
En raison de l’absence d’anémie importante associée à un éventuel hyperœstrogénisme, un traitement chirurgical est entrepris avec succès.
Les trois furettes ont reçu une prémédication (buprénorphine à 0,05 mg/kg, méloxicam à 0,2 mg/kg, midazolam à 0,3 mg/kg). Une anesthésie gazeuse est utilisée (isoflurane et oxygène).
Le traitement consiste en une ovariohystérectomie selon une méthode classique : ligature puis résection des pédicules ovariens, ligatures indépendantes des vaisseaux utérins et du vagin proximal puis résection de ces derniers, fermeture de la cavité abdominale en trois plans (musculaire, sous-cutané et cutané).
Le volume de la tumeur retirée est très important pour les furettes 2 et 3 (12 cm environ de diamètre) (Photos 3A à 3C) et modéré (4 centimètres) pour la furette 1.
L’analgésie a été prolongée durant trois jours postopératoires. Les trois furettes ont rapidement récupéré de l’opération.

Photo 3A - Furette 1 : Temps peropératoire et observation des tumeurs ovariennes des furettes 1 (A), 2 (B) et 3 (C).

Photo 3B - Furette 2

Photo 3C - Furette 3
Diagnostic définitif et évolution
L’analyse histopathologique conclut à un léïomyosarcome ovarien pour les trois furettes (Photo 4).
La convalescence se passe bien pour les trois. L’œdème vulvaire disparaît dans les trois semaines suivant la chirurgie.
La repousse des poils est complète dans les 4 à 6 semaines postopératoires.
Les trois furettes sont décédées de mort naturelle huit mois à deux ans après la chirurgie sans signe de complication.
Photo 4 : Vue microscopique (HE, grossissement x 40) d’une coupe histologique d’une masse montrant une tumeur mésenchymateuse.
L’anisocytose et l’anisocaryose sont modérées et quelques atypies sont observées. Les mitoses sont peu nombreuses.